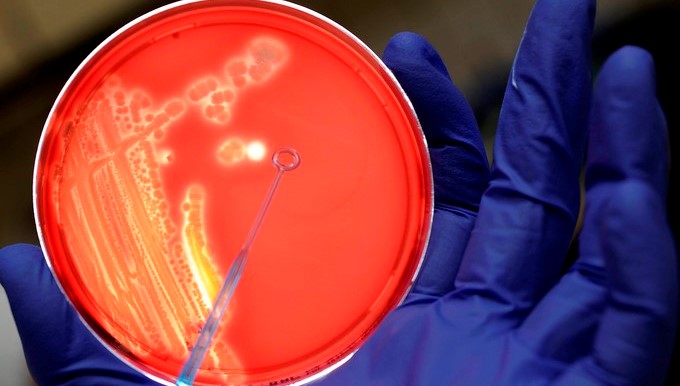

-Un asistente de laboratorio examina una colonia de bacterias
Las bacterias, como los seres humanos, sienten el ambiente, un descubrimiento que puede llevar al desarrollo de mejores medicamentos contra infecciones bacteriales, según expertos de la Universidad de Colorado (CU) en Boulder.
El hallazgo, difundido hoy y considerado como “la primera observación documentada” del sentido del tacto en bacterias individuales, es el resultado de un estudio realizado por investigadores de Boulder con bacterias E.coli.
Según Giancarlo Bruni, candidato a doctorado en el Departamento de Biología Molecular, Celular y de Desarrollo en CU, tanto las bacterias como los humanos utilizan pequeños impulsos eléctricos generados por iones de calcio para transmitir información del ambiente circundante al sistema nervioso y sensorial (o su equivalente bacterial).
Los humanos y las bacterias “no somos tan diferentes”, comentó Bruni sobre el descubrimiento, publicado en la revista especializada Proceedings of the National Academy of Sciences y realizado en conjunto con Joel Kralj, Andrew Weekley y Benjamin Dodd.
Los científicos ya sabían que las bacterias reaccionan a su ambiente y se comportan de manera distinta si, por ejemplo, tienen acceso a azúcar o no, o si están sobre una superficie rígida o blanda.
Pero el nuevo estudio encontró que las bacterias “sienten” su ambiente. Para comprobarlo, Bruni y sus colaboradores colocaron a las bacterias E. coli dentro de una superficie pegajosa y las observaron con un microscopio.
Si nada tocaba a las bacterias, se mantenían “apagadas”. Pero si se las tocaba o empujaba, se “encendían”, es decir, emitían una tenue luz indicando que dentro de la bacteria se estaba usando electricidad para transmitir información.
“Creemos que lo que podría estar sucediendo es que las bacterias usan esas señales eléctricas para modificar su estilo de vida”, explicó el profesor Kralj, quien también es parte del Instituto BioFrontiers en CU-Boulder.
Eso significa que bacterias y humanos comparten “una herramienta común para sentir el ambiente circundante”, las señales eléctricas.
Es así que los orígenes del sistema neuronal humano, desde una perspectiva evolutiva, se remontarían a “miles de millones de años”, ya que claramente están presentes entre los organismos más antiguos del planeta.
Pero también significa que la “herramienta común” ahora podría usarse en contra de las bacterias, ya que es precisamente esa herramienta la que les permite a ciertas bacterias sobrevivir a los antibióticos y eventualmente volverlos inoperantes.
Por eso, el siguiente paso del estudio, según los investigadores, será determinar de qué manera las bacterias usan sus impulsos eléctricos para infectar células humanas.
“Si bloqueamos la actividad eléctrica bacterial, quizá las bacterias tengan menos posibilidades de infectar”, básicamente, porque no sabrán dónde están y, por lo tanto, tampoco sabrán cómo actuar, afirmó Kralj.
EFE
- Compartir:
- Compartir en Facebook
- Compartir en X (Twitter)
- Compartir en WhatsApp
- Comentarios


